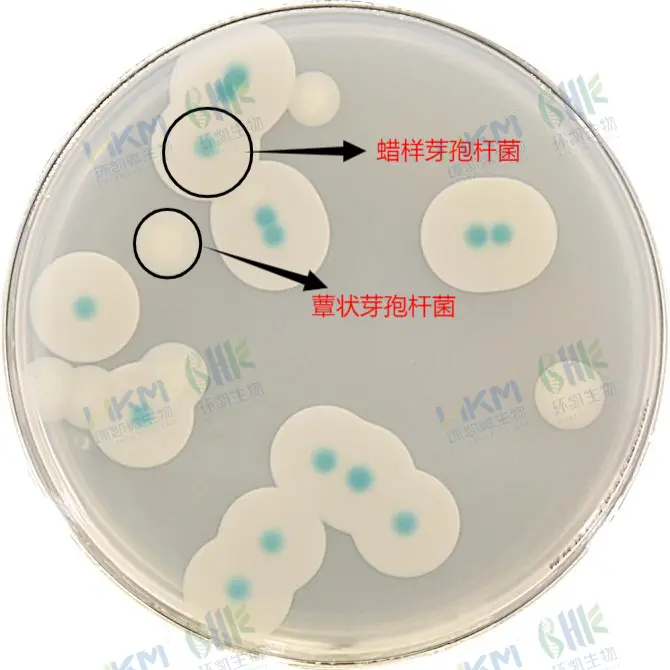
蜡样芽孢杆菌显色培养基

蜡样芽孢杆菌检测不用愁!环凯一站式方案来解忧
发布时间:2026-01-15 浏览次数:866 分享:
蜡样芽孢杆菌是一种具有高度热稳定性的食源性致病菌,其产生的耐热毒素可导致婴幼儿出现呕吐、腹泻等症状,严重情况下可能引发脱水甚至更危险的后果。
环凯为食品企业实现对蜡样芽孢杆菌的全面、精准管控,打造了从采样前处理到最终确认的全链条检测解决方案,确保每个环节都能有效防控风险。
一、表面采样前处理:筑牢污染源头防控线
一次性采样管(采集转运拭子)作为环境采集的关键工具,具备以下核心技术参数与优势:
该系列产品的主要技术参数包括:
- 一体化密封设计:将拭子与灭菌稀释液或培养基整合为一体,避免采样过程中出现污染,保障样本完整性。
- 便捷区分设计:采用彩色盖子,外观醒目,便于快速区分不同型号的产品,提升采样效率。
- 高效采样材质:拭子头采用聚酯海绵材质,具有优异的微生物吸附能力与释放性能,确保能充分采集并保留样本中的微生物。
- 精准定量设计:管身自带清晰刻度,可精准定位取样量,为后续检测的定量分析提供支持。
- 保护样本活性:不含生物灭杀剂,能有效收集生物样本并维持其生物活性,确保检测结果的真实性。
- 种类丰富:有含复方中和剂磷酸盐缓冲液、磷酸盐缓冲液、生理盐水、缓冲蛋白胨水等。

二、蜡样芽孢杆菌显色培养基的应用
针对蜡样芽孢杆菌的快速、准确检测需求,我司研发的CRM005蜡样芽孢杆菌显色培养基提供种高效的技术解决方案。该产品以特异性酶与显色底物的反应为核心原理,通过独特的显色特征,实现对目标菌的快速分离与初步鉴别。
1)检测原理
CRM005蜡样芽孢杆菌显色培养基的核心原理是利用微生物自身代谢产生的酶与特定显色底物的特异性反应。显色剂与蜡样芽孢杆菌具有的酶发生特异性反应,水解底物,释放出显色基团,使菌落呈现蓝绿色。
2)技术优势
CRM005蜡样芽孢杆菌显色培养基的主要技术优势体现在以下几个方面:
① 检测速度快:传统检测方法(如 GB 4789.14-2014 标准)所采用的甘露醇卵黄多粘菌素(MYP)琼脂,培养周期需 24 至 48 小时,而蜡样芽孢杆菌显色培养基将培养时间缩短至 24 小时,有效提高了检测效率,为食品安全管控争取了宝贵时间。
② 特异性高,降低误判风险:该培养基能够精准区分蕈状芽孢杆菌与蜡样芽孢杆菌亲缘关系较近的菌种,显著降低了假阳性检测结果的出现概率,让检测数据更具参考价值。
显色培养基作为快速初筛工具,可显著缩短检测周期,但最终结果仍需结合生化鉴定或分子生物学技术进行验证与确证,形成协同检测合力。
三、可疑菌落鉴定
1)EasyID生化鉴定试剂盒
HKI003 EasyID蜡样芽孢杆菌生化鉴定试剂盒基于GB 4789.14-2014标准研发,采用一步加样技术,可同时完成10项关键生化反应测试,包括:甘溶菌酶、甘露醇、葡萄糖、淀粉、硝酸盐、VP、动力、柠檬酸盐、明胶和3%过氧化氢实验。
该试剂盒的核心优势的体现在:
- 操作标准化:预制好的生化鉴定条和配套试剂,确保每批次检测条件一致,结果可比性强;
- 易于操作:一次加样即可覆盖所有检测孔,无需逐孔接种,大幅减少操作步骤与工作量;
- 低污染率:一步加样模式避免了错加、漏加试剂以及手部接触带来的污染风险;
- 易于判读:配备大角度观察窗,阳性与阴性结果对比明显,便于工作人员快速、准确记录结果。
在实际检测中,可疑菌落经显色培养基初筛后,可通过该生化鉴定试剂盒进行进一步验证,有效提升检测结果的准确性。

2)环凯蜡样芽孢杆菌核酸检测试剂盒
FZ023BF2 蜡样芽孢杆菌核酸检测试剂盒(PCR-荧光探针法)基于实时荧光PCR技术,针对检测目标特异性基因片段设计引物和荧光探针并优化反应所需试剂组分,加入待检样品核酸即可进行扩增反应。在扩增过程中,荧光探针与目的基因片段结合,可被Taq酶分解并产生荧光信号,此时荧光定量PCR仪可识别该荧光信号,同时根据其强弱变化绘制出相应的实时扩增曲线,进而判定目标基因是否检出,具有以下技术特点:
- 快速提取:一步法核酸提取,快速高效,核酸提取效率高;
- 操作简单:提供PCR反应体系预混液,直接加样检测,无需自行配制;
- 特异性强:采用高特异性引物及探针,确保实验准确性;
- 灵敏度高:采用高效的扩增酶,检测灵敏度可达10-100copies/test。
此方案整合采样、前处理、专用显色培养基、生化试剂盒及PCR试剂盒等产品,形成"采样+快速初筛+精准验证"的技术闭环,满足食品生产企业不同检测场景的需求。

环凯一站式蜡样芽孢杆菌检测方案产品目录:
| 用途 | 产品类型 | 货号 | 名称 | 规格 |
| 表面采样 | 即用型 | CY002 | HK-BPW一次性采样管(采集转运拭子)(10mL缓冲蛋白胨水) | 10 mL×50支 |
| CY004 | HK-PBS一次性采样管(采集转运拭子)(10mL磷酸盐缓冲液) | 10 mL×50支 | ||
| CY005 | HK-N-PBS一次性采样管(采集转运拭子)(10mL含复方中和剂磷酸盐缓冲液) | 10 mL×50支 | ||
| 样品稀释 | 干粉 | 022117 | 磷酸盐缓冲液(PBS) | 250g |
| 即用型 | CP0511A | 磷酸盐缓冲液(PBS) | 225mL×6瓶 | |
| CP0640 | 磷酸盐缓冲液(PBS) | 225mL×10袋 | ||
| C22117G1 | 磷酸盐缓冲液(PBS) | 9mL×20支 | ||
| CP0630 | 生理盐水 | 225mL×10袋 | ||
| CP0310 | 生理盐水 | 9mL×20支 | ||
| 计数 | 干粉基础 | 028380 | 甘露醇卵黄多粘菌素琼脂基础(MYP) | 250g |
| 024051 | 胰蛋白胨大豆肉汤(胰酪胨大豆多粘菌素B肉汤基础) | 250g | ||
| CRM005 | 蜡样芽孢杆菌显色培养基及配套试剂 | 1000mL | ||
| 添加剂 | SR0170 | MYP及胰酪胨大豆多粘菌素B肉汤配套试剂 | 10支 | |
| 029250 | 50%卵黄液 | 5mL×5支 | ||
| 即用型 | 028381 | 甘露醇卵黄多粘菌素琼脂平板 | 90mm×20个 | |
| CP0212 | 胰酪胨大豆多粘菌素B肉汤培养管 | 10mL×20支 | ||
| CP0740 | 胰酪胨大豆多粘菌素B肉汤 | 225mL×10袋 | ||
| CP0423 | 胰酪胨大豆多粘菌素B肉汤培养基 | 225mL×6瓶 | ||
| CRM005A | 蜡样芽孢杆菌显色平板培养基 | 90mm×20个 | ||
| 纯培养\根状生长 | 干粉 | 022020 | 营养琼脂(羊血琼脂基础) | 250g |
| 颗粒 | 022020P1 | 营养琼脂(羊血琼脂基础)(颗粒型) | 250g | |
| 即用型 | 024089 | 营养琼脂平板 | 90mm×20个 | |
| 革兰氏染色 | 即用型 | 029010 | 革兰氏染色液 | 10mL×4支 |
| 溶血实验 | 即用型 | CP0800 | 胰酪胨大豆羊血(TSSB)琼脂平板 | 90mm×20个 |
| 蛋白质毒素结晶实验 | 干粉 | 022023 | 硫酸锰营养琼脂 | 250g |
| 即用型 | 029063 | 蛋白质毒素结晶体染色液 | 10mL | |
| 酪蛋白分解 | 干粉 | 028370 | 酪蛋白琼脂 | 250g |
| 即用型 | CP0172 | 酪蛋白琼脂平板 | 90mm×20个 | |
| 生化 | 试剂盒 | HKI003 | EasyID蜡样芽孢杆菌生化鉴定试剂盒 | 11种×10测试 |
| 质控菌种 | 阳性对照 | FSCC115002 | 蜡样芽孢杆菌 | 1支冻干菌+1支复苏液 |
| 阴性对照 | FSCC115030 | 蕈状芽孢杆菌 | 1支冻干菌+1支复苏液 | |
| FSCC115055 | 苏云金芽孢杆菌 | 1支冻干菌+1支复苏液 | ||
| FSCC149005 | 大肠埃希氏菌 | 1支冻干菌+1支复苏液 | ||
| 蜡样芽胞杆菌快速检测 | FZ023BF2 | 蜡样芽孢杆菌核酸检测试剂盒(PCR-荧光探针法) | 48 测试/盒 | |